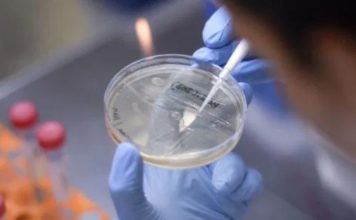

Tres probables casos de la variante Delta en Santo Tomé
«Todavía no está confirmada la variante Delta, porque eso se manda al Malbrán» confirmó el Secretario de Salud de Santo Tomé, Daniel Susmann. El pasado fin de semana, desde el Ministerio de Salud de la provincia de Santa Fe detectaron 3 casos positivos de una probable variante Delta en personas oriundas de la localidad de … Sigue leyendo Tres probables casos de la variante Delta en Santo Tomé